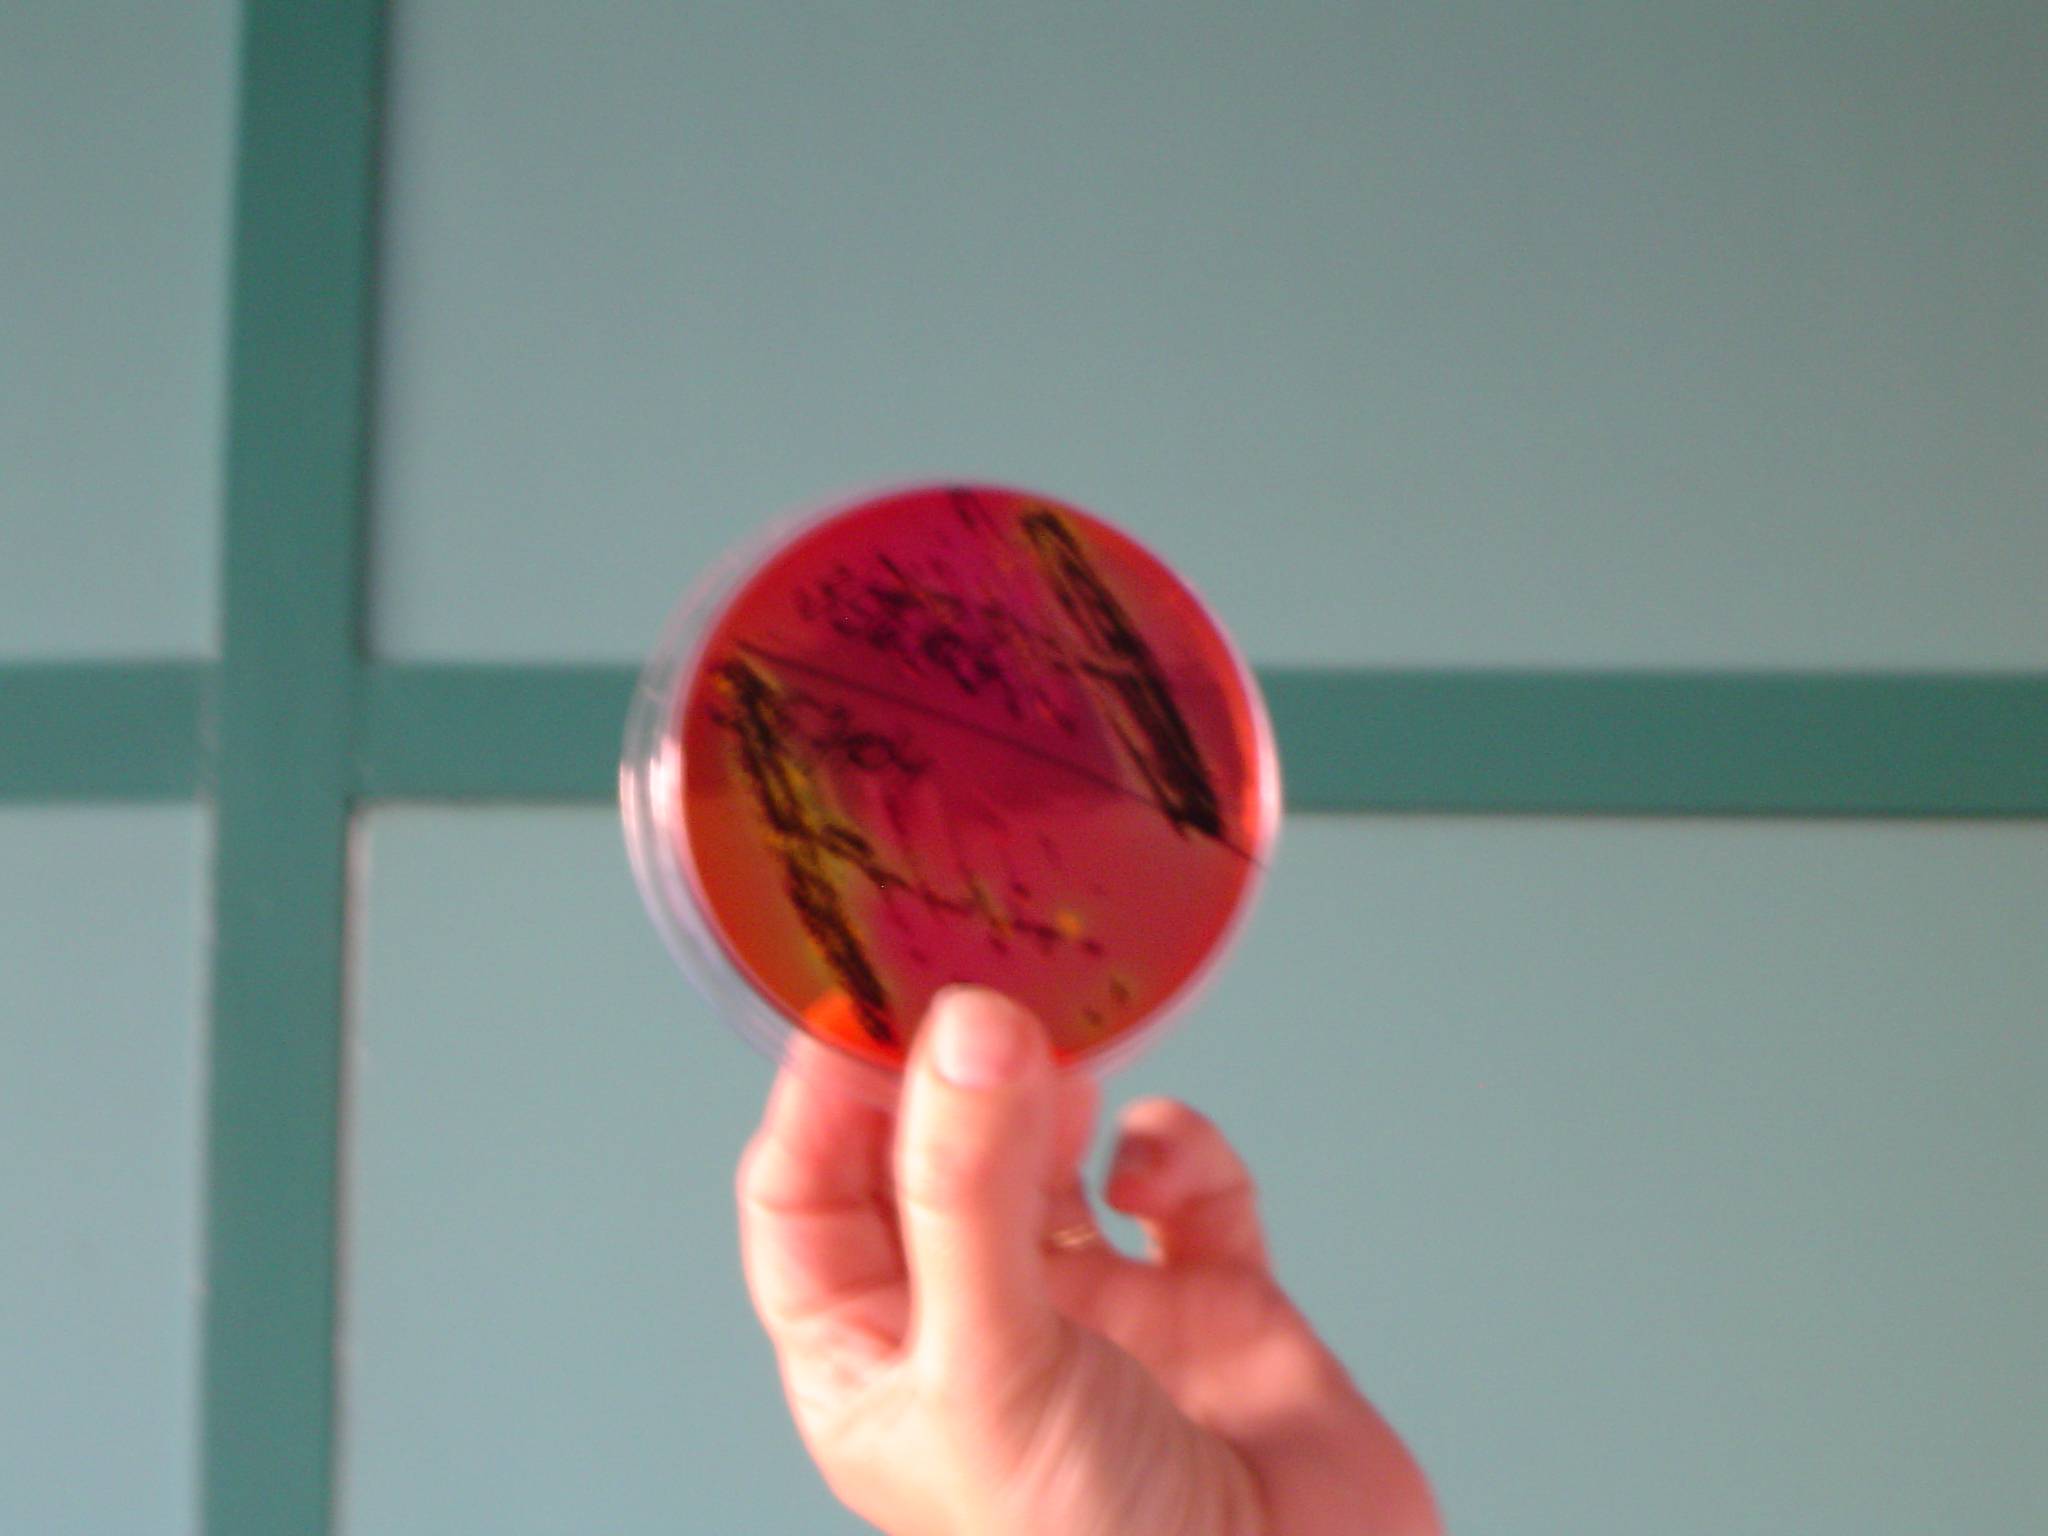

Muzej krapinskih neandertalaca
Terenska nastava osmih razreda – 19.listopada 2021.


Odgojno – obrazovni ishodi:
BIO OŠ B.8.3. Analizira utjecaj životnih uvjeta na razvoj prilagodbi i bioraznolikost
- razlikuje kemijsku i biološku evoluciju
- na temelju fosilnih dokaza donosi zaključke o evoluciji čovjeka
- opisuje čovjekovu evoluciju kao nedjeljiv dio evolucije života na Zemlji
BIO OŠ D.8.1. Primjenjuje osnovna načela znanstvene metodologije i objašnjava dobivene rezultate
- promatra i prikuplja podatke te donosi zaključke tijekom učenja i poučavanja.
- proučava različite izvore procjenjujući točnost informacija u odnosu prema usvojenome
znanju.
- odabire pouzdane izvore informacija
Ciljevi
- upoznati se s nalazima neandertalaca u Hrvatskoj
- poticati radoznalost i razvijati znanstveni pogled na svijet



Unatoč, ponovno pandemijskoj godini uspjeli smo realizirati terensku nastavu iz biologije. Puno smo toga vidjeli, čuli i naučili, a nakon povratka sve to rezimirali, ponovili i sami nešto napravili.

Biologija VII. Razred;
Tema: Najjednostavniji oblici života na zemlji
Iz svakog odjela VII. razreda sudjelovalo 5-7 učenika koji su stečena znanja prenijeli ostalim učenicima u razredu. Svoje izvješće potkrijepili su i video zapisom, te organizirali praktičan rad – uzgoj bakterija na hranjivom agaru (otisci prstiju, bakterije iz usne šupljine – štapić za uši ili bris žvakaće gume, bakterije iz zraka). Izradili su i plakat o bakterijama (građa, razmnožavanje, oblici…) i plakat o posjetu mikrobiološkom laboratoriju.
Zadaci izvanučionične nastave bili su saznati:
-
kako izgleda mikrobiološki labaratorij
-
koje uređaje i aparate mora imati svaki mikrobiološki laboratorij
-
Koje su zadaće mikrobiloškog laboratorija; čime se zapravo bave
-
Što su hranjive podloge i kakve hranjive podloge postoje
-
Zašto se uzima bris, grla, nosa …
-
Kako se uzimaju brisevi i njihovo pravilno nacjepljivanje na hranjivu podlogu
-
Čemu služi bakteriogram
-
U kojem vremenu se i pri kojim uvjetima razviju bakterije na hranjivoj podlozi
Što čine sa hranjivim podlogama na kojima su se razvile bakterije

Izvanučionička nastava iz biologije za učenike VII.a razreda, Terenski rad je organiziran u sklopu nastavne teme – Ptice; Raznolikost ptica, s ciljem upoznavanja učenika s najčešćim vrstama ptica u našem okolišu, njihovim prilagodbama, utjecajima čovjeka na okoliš, a time i na njihova staništa. Također zadaća nastave bila je i upoznavanje s radom ornitološkog društva kao i s postupkom i značenjem prstenovanja.
Učenike je najprije član ornitološkog društva upoznao s radom samog društva, kao i sa samim postupkom prstenovanja.

Nakon obilaska mreža, gdje im je najteže bilo održavati tišinu, a koja je bila nužna kako se uhvaćene ptice ne bi ozlijedile, vidjeli su i sam postupak prstenovanja i vođenje zabilješki o provedenom postupku.



U nastavku našeg terenskog rada rješavali su radni listić čiji se sadržaj odnosio na mreže, njihov raspored, razumijevanje važnosti prstenovanja, sam postupak prstenovanja i određivanje vrsta ptica prstenovanih za vrijeme našeg boravka na terenu. Analizom rezultata provedenog listića dobila sam potvrdu kako su svi, gore navedeni ciljevi ovog terenskog rada bili uspješno ostvareni.

PRIRODA VI. RAZRED - IZVANUČIONIČNA NASTAVA
BILJKE I GLJIVE U ŠUMI; ŽIVOTINJE U ŠUMI
- radni listovi iz: Priroda 6, terenska nastava za šesti razred osnovne škole (V. Bošnjak, R. Bule, V. Seljanec, J. Tokić)
-učenike podijeliti na šest grupa
Radni listovi.
- Životni uvjeti u šumi
- Promatranje prizemnog sloja – biljke i gljive, životinje
- Promatranje sloja grmlja – biljke i životinje
- Promatranje sloja drveća u šumi
- Promatranje biljke
Ishodi:
-Upoznati obilježja kontinentalne listopadne šume
-Uočiti slojeve šume
-Prepoznati biljke kontinentalne listopadne šume
-Razlikovati jestive i otrovne gljive
-Opisati prilagodbe biljaka na uvjete u određenom staništu
-Prepoznati najčešće životinje i uočiti njihove prilagodbe






IZVANUČIONIČNA NASTAVA , PRIRODA V. RAZRED
Tema: Uzgoj i zaštita biljaka i životinja
Nastavna jedinica: Biljke u prehrani
Festival kruha i slastica (Zagrebački velesajam)
Cilj:
zaključiti na temelju iskustvenog doživljaja da su žitarice najvažnije čovjekove prehrambene biljke
upoznati različite vrste žitarica (pšenica, kukuruz, zob, raž, ječam, riža)
saznati što se podrazumijeva pod ekološkim uzgojem
naučiti što je to biološki uzgoj
shvatiti u čemu je razlika između bijelog i crnog brašna
zaključiti je li zdraviji bijeli ili crni kruh




TERENSKA NASTAVA
MUZEJ KUKACA – VARAŽDIN, ARBORETUM OPEKA
BIOLOGIJA VII. RAZRED
NASTAVNE CJELINE:
Razvoj mnogostaničnih životinja; Kukci i ostali člankonošci
Razvoj biljaka; Mahovine; Papratnjače; Golosjemenjače; Kritosjemenjače;
- realizacija terenske nastave tijekom nekoliko nastavnih godina; integracija s likovnom kulturom ili geografijom
ZADACI:
- razvijati interes za prirodu i živa bića u njoj
- razvijati pravilan odnos prema zaštiti i očuvanju prirode
- shvatiti da su kukci najbrojnija skupina životinja na kopnu i njihovo značenje u prirodi i životu čovjeka
- povezati prilagodbe kukaca na životne uvjete
- opisati preobrazbu kukaca
- osposobljavati učenike za rad u grupi
- utvrditi stečena znanja o sistematici biljka
- upoznavanje sa specifičnim biljnim vrstama u arboretumu (stručno vodstvo)
- povećati interes i znanja djece o prirodno-geografskoj osnovi Panonske nizine i njenog rubnog prostora
- na primjeru Drave ponoviti i utvrditi pojmove slijeva, porječja, vodostaja, riječnog režima i protoka, te raspraviti o važnosti energije te potrebi stvaranja hidroelektrana
- odrediti prometni položaj Varaždina u okviru europskih prometnih pravaca
- upoznati djecu sa značenjem funkcija grada u organizaciji prostora, s naglaskom na Varaždin i Čakovec kao izrazito pozitivne primjere u nastojanju izbjegavanja jačanja centraliteta glavnog grada
- navesti kulturno-povijesne spomenike i društvene atrakcije kao elemente prosperitetnog turističkog razvoja gradskog turizma u okvirima kontinentalnog turizma


Učenicima su nakon razgleda Muzeja kukaca podijeljeni radni listići koje su istražujući rješavali sami ili u timu, koristeći se pri tome građom muzeja. U radu su pokazali zavidnu razinu snalažljivosti, domišljatosti i spretnosti.
Nakon obavljenih zadataka u arboretumu – radni listići iz biologije i geografije, te likovne radionice ostalo je vremena i za igru i zabavu.



IZVANUČIONIČNA NASTAVA U ŠKOLI NAD LIPOM - VIII.razred.
Nastavna tema: Nasljeđivanje;
Promjene u nasljednom materijalu – nasljedne bolesti, Downov sindrom
Učenici su upoznali djecu polaznike ove škole, a među njima i onu s Downovim sindromom. Pedagoginja škole nas je dočela i u uvodnom dijelu upoznala s osnovnim podacima o školi, organizacijom i načinom rada i odgovorila na veliki broj postavljenih pitanja. (Koliko učenika ima u razredu, a koliko u tzv. skupinama?, Koje predmete imaju?, Koliko sati u jednom danu?, Da li se svi uspiju osposobiti za samostalan život? Do koje godine ostaju u školi?, …)
Poslije razgovora u pratnji pedagoginje išli smo u obilazak škole, ulazili u razrede, upoznavali se s učenicima, razgledavali njihove uratke i na taj način stekli uvid o njihovim sposobnostima.
Vrlo izražena komunikativnost djece s Downovim sindromom i opuštenost naših učenika rezultirala je druženjem, veseljem i smijehom.
Djeci u školi Nad Lipom unijeli smo malo veselja i promijenili svakodnevicu, a naši su učenici postali bogatiji za jedno novo iskustvo.
Jedan dio učenika pokazao je interes za daljnje druženje pa sam s pedagoginjom škole dogovorila daljnju suradnju, koja će se realizirati u zajedničkim likovnim i keramičkim radionicama.





TERENSKA NASTAVA
MUZEJ KRAPINSKIH NEANDERTALACA
BIOLOGIJA VIII. RAZRED
NASTAVNA CJELINA:
PODRIJETLO ČOVJEKA
- realizacija terenske nastave tijekom nekoliko nastavnih godina; integracija s likovnom kulturom
ZADACI:
- upoznati se s nalazima neandertalca u Hrvatskoj
- na temelju fosilnih nalaza i drugih dokaza donijeti zaključke o evoluciji čovjeka
- shvatiti da je čovjekova evolucija nedjeljiv dio evolucije života na Zemlji
- poticati radoznalost i razvijati znanstveni pogled na svijet


O DEDEKU KAJBUMŠČAKU...
Popularan krapinski pračovjek ili "dedek Kajbumščak" , znanstveno poznat kao Homo sapiens neanderthalensis , otkriven je 1899. godine kada su započela geološka i paleontološka istraživanja na
Hušnjakovom brdu u Krapini.
Iskapanja su trajala šest godina pod nadzorom profesora Dragutina Gorjanovića-Krambergera, poznatog hrvatskog geologa, paleontologa i paleoantropologa. Polušpilja u Krapini ubrzo se uvrstila u znanstvene lokalitete svijeta kao bogato fosilno nalazište na kojem je prikupljena najbrojnija i najbogatija zbirka neandertalskog čovjeka. U naslagama špilje, visine oko osam metara, nađeno je oko devet stotina ljudskih fosilnih kostiju, koje pripadaju fosilnim ostacima više desetaka individua različitog spola i životne dobi od 2 do 40 godina.
Nađeni su i brojni fosilni ostaci špiljskog medvjeda, vuka, losa, golemog jelena, toplodobnog nosoroga, divljeg goveda i mnogih drugih životinja. Više od tisuću pronađenih komada kamenog oruđa iz razdoblja paleolitika, odnosno starijeg kamenog doba, svjedoči o materijalnoj kulturi krapinskog pračovjeka. Starost ovog bogatog paleontološkog lokaliteta odgovara vremenu od prije 130 000 godina. O tumačenju krapinskog nalazišta postoje različite teorije koje su i danas predmet brojnih paleoantropoloških rasprava. Nakon više od stoljetnog postojanja ono je osobito atraktivno upravo zbog svoje paleontološke važnosti i velikog broja fosilnih uzoraka. Zaštićeno je i kao prvi paleontološki spomenik prirode u Hrvatskoj, te uvršteno u jedno od najbogatijih paleolitskih staništa neandertalskog čovjeka u svijetu.



Pješačenjem do špilje Veternice na Medvednici obilježili smo Europski tjedan mobilnosti (16. do 22. rujna) a posjetom iste upoznali smo se, uz stručno vodstvo, sa načinom života šišmiša, uvjetima u kojima žive, te vrstama koje obitavaju na tom području.
Time smo obilježili i Međunarodnu noć zaštite šišmiša 21.09, kao i Međunarodnu godinu šišmiša 2011-2012.
Saznali smo puno toga o životu tih neobičnih sisavaca, ali našli vremena i za druženje i zabavu na koju su neki spremni u svim situacijama.




TERENSKA NASTAVA
FARMA NOJEVA – KOZARICE , ERGELA KONJA U LIPIKU
PRIRODA V. RAZRED
CJELINA: UZGOJ I ZAŠTITA BILJAKA I ŽIVOTINJA; UZGOJ ŽIVOTINJA
ZADACI:
- upoznati način uzgoja životinja na farmama kroz iskustveni doživljaj
- uočiti koje koristi čovjek ima od životinja
- istaknuti načine njihove zaštite
- shvatiti važnost humanog pristupa u uzgoju životinja
- usvojiti pojam autohtone pasmine
- uočiti važnost češćeg boravak u prirodi
- izgrađivati ekološku svijest
- razvijati toleranciju i prijateljstvo




Učenicima se nakon dolaska obratila voditeljica OPG-a upoznavši ih s pravilima ponašanja na farmi, nakon čega im je omogućen izravan kontakt s nojevima.
Bilo je vrlo hrabrih, ali i onih koje je hrabrost napustila s približavanjem prvog noja. Uživali su u druženju s velikim i neobičnim pticama koje su mogli dodirivati, promatrati iz neposredne blizine i hraniti.
Voditeljica je odgovarala na njihova mnogobrojna pitanja pokušavajući u potpunosti zadovoljiti dječju znatiželju, pobuđenu novom situacijom i novim prostorom.
Nakon rješavanja i analize radnog listića iz prirode slijedila je likovna radionica.

Svaki je učenik oslikao komadić ljuske nojeva jaja, koji je nakon završne obrade – sušenja, lakiranja i stavljanja na vezicu postao prekrasan privjesak. Tako su sa sobom osim novo stečenih znanja i iskustava kući odnijeli i uspomenu na taj dan.
Posjetili smo i ergelu u Lipiku i naučili da je ergela stočarsko gospodarstvo na kojem se uzgajaju visokokvalitetni konji. Za vrijeme boravka u ergeli učenici su razgledali staje s konjima,saznali kako protječe jedan dan na ergeli te saznali koje su obaveze zaposlenika. Imali su prilike vidjeti i žigosanje konja, prizor kojima se većini nije svidio i za koji su odreda izjavili da bi ga trebalo zabraniti.
(U Hrvatskoj je od 2009.godine propisano označavanje kopitara mikročipom, no i dalje je dopušteno vruće paljenje žigom, iako je to nepouzdan, zastarjeli i nehuman način označavanja životinja i dokazivanja vlasništva.)


Prekrasno ždrijebe – Maja osvojila je simpatije svih učenika.

| « Siječanj 2026 » | ||||||
| Po | Ut | Sr | Če | Pe | Su | Ne |
| 29 | 30 | 31 | 1 | 2 | 3 | 4 |
| 5 | 6 | 7 | 8 | 9 | 10 | 11 |
| 12 | 13 | 14 | 15 | 16 | 17 | 18 |
| 19 | 20 | 21 | 22 | 23 | 24 | 25 |
| 26 | 27 | 28 | 29 | 30 | 31 | 1 |
| 2 | 3 | 4 | 5 | 6 | 7 | 8 |





































.png)



